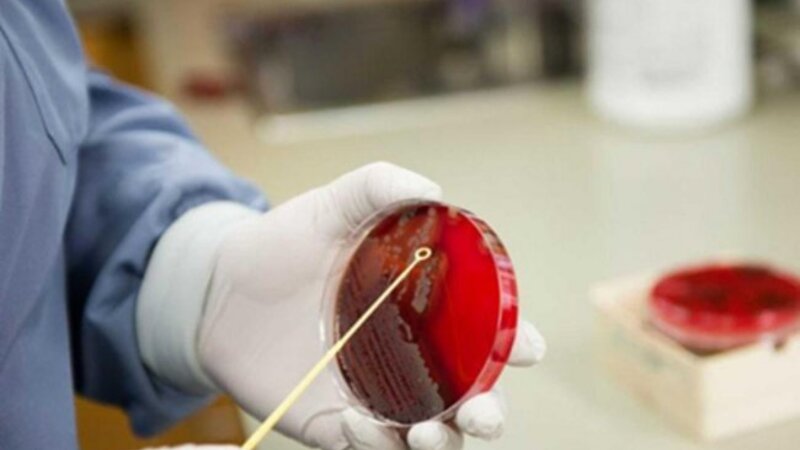

BAKI, 20 dekabr. TELEQRAF
ABŞ hökumətinin Qərbi Afrikanın Qvineya-Bisau ölkəsində hepatit B peyvəndi ilə bağlı 1,6 milyon dollarlıq tədqiqat aparmaq planı beynəlxalq ekspertlər tərəfindən kəskin tənqid olunub.
Teleqraf xəbər verir ki, tədqiqat ABŞ Prezidenti Donald Tramp administrasiyasının qərarı ilə maliyyələşdiriləcək. Mütəxəssislər bu təşəbbüsü qeyri-etik, son dərəcə riskli və neokolonialist yanaşma kimi qiymətləndiriblər.
Tədqiqat Qvineya-Bisauda yeni doğulan körpələrin bir hissəsinə hepatit B peyvəndinin vurulması, digər hissəsinə isə vurulmaması prinsipi ilə aparılacaq. Halbuki Ümumdünya Səhiyyə Təşkilatı (ÜST) hepatit B peyvəndinin bütün körpələrə doğuş zamanı vurulmasını tövsiyə edir.
Duke Universitetinin Qlobal Sağlamlıq İnstitutunun professoru Gavin Yamey bildirib ki, artıq doğuş zamanı peyvəndin effektivliyini sübut edən tədqiqatlar mövcuddur və belə bir sınağın aparılması elmi etikaya ziddir.
Filadelfiya Uşaq Xəstəxanasının peyvənd üzrə mütəxəssisi Pol Offit isə deyib ki, sübut olunmuş təhlükəsiz peyvəndin bəzi uşaqlara qəsdən verilməməsi ağlasığmaz dərəcədə etik pozuntudur.
Məlumata görə, Qvineya-Bisauda böyüklərin təxminən 18 faizi hepatit B virusuna yoluxub, bu isə peyvəndsiz körpələr üçün yüksək risk yaradır. Araşdırmalar göstərir ki, virusla ilk ildə yoluxan uşaqların 90 faizi gələcəkdə qaraciyər sirrozu və ya xərçəng riski ilə üzləşir.
Tənqidçilər bildirirlər ki, ABŞ-nin qlobal peyvənd proqramlarına maliyyəni azaltması fonunda belə bir tədqiqat aparması beynəlxalq səhiyyə ictimaiyyətində etimadı daha da sarsıdır.
Ekspertlərin fikrincə, prioritet peyvəndlərin sınaqdan keçirilməsi deyil, daha çox uşağın doğuş zamanı peyvəndlə təmin olunması olmalıdır.










.jpg)

































